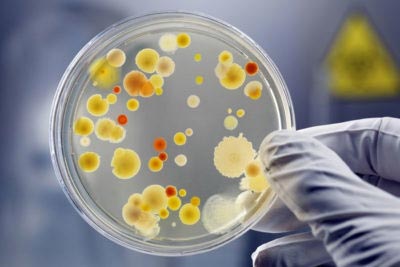

Більшість людей думає, що для підтвердження дисбактеріозу кишечника вистачить одного аналізу калу, але це помилкове припущення. Незважаючи на те, що біохімічний аналіз калових мас є основним способом підтвердження діагнозу, це не єдиний діагностичний метод. Якщо ви збираєтеся здати цей посів, необхідно попередньо ознайомитися з правилами збирання і здавання біоматеріалу, прайс-листом і тими місцями, де можуть виконати даний аналіз.
Зміст
- 1 Коли потрібне обстеження
- 2 Вартість дослідження
- 3 Важливі правила здачі
- 3.1 Бактеріологічний посів
- 4 Розшифровка дослідження
- 5 Діагностика піхвової мікрофлори
Коли потрібне обстеження
Біохімічний аналіз калу на дисбактеріоз потрібно зробити в тому випадку, якщо недуга не вщухає самостійно протягом чотирьох днів. Крім цього, кал на дисбактеріоз здається при наявності таких симптомів: зневоднення, лихоманка, кишкова кровотеча.
Аналіз на дисбактеріоз кишечника роблять у разі такої клінічної картини:
- каловий стілець дуже рідкий, водянистий протягом довгого часу;
- мовою є наліт;
- почуття постійної нудоти, блювання;
- хворобливі відчуття і дискомфорт в області кишечника;
- у стільці присутній слиз, кров;
- колір калу сірий, чорний;
- лихоманка;
- зневоднення організму;
- помилковий позив до акту дефекації;
- шкірний висип;
- неприємний запах з ротової порожнини.
Оцінивши результати проведеного тесту, лікар зможе призначити спеціальне дослідження калу на наявність крові – гемотест, а також на стафілокок, эшеихии, клостридії та інше. Не слід самостійно вибирати аналізи для здачі, так як можна упустити важливі з них і зробити зайві.
Вартість дослідження

Аналіз на дисбактеріоз можна здати в будь-якій лабораторії. Наприклад, гарною репутацією користується лабораторія Інвітро в Москві. Перш ніж вибрати ту або іншу лабораторію, необхідно дізнатися ціни на аналіз, а також зібрати відгуки про якість досліджень.
Цінова політика в кожній клініці і лабораторії різна. Середня вартість аналізу на дисбактеріоз в державних лабораторіях становить 200 рублів, у приватних – не менше 800 рублів.
Якщо ви збираєтеся здати аналіз калу на дисбактеріоз, то вас чекають наступні фінансові витрати в залежності від міста, де ви проживаєте:
- Москва – 400-1200 рублів;
- Самара – 670-100 рублів;
- Санкт-Петербург – 900-1000 рублів;
- Перм – 340-700 рублів;
- Воронеж – 800-900 рублів;
- Казань – 600-650 рублів;
- Єкатеринбург – 270-900 рублів;
- Волгоград – 180-400 рублів;
- Красноярськ – 460-900 рублів.
Важливо знати, що результати аналізу калу на дисбактеріоз будуть готові через п’ять-сім діб. Тривалість аналізу обумовлена технікою його виконання. Мінімальний термін виконання аналізу становить п’ять днів.
Важливі правила здачі
Для аналізу потрібна грамотна підготовка. Від цього етапу може залежати результат аналізу. Підготовка передбачає дотримання певної дієти за 3 дні до здачі. Бажано виключити з раціону буряк, кава, алкоголь, рибні і м’ясні страви, борошняні вироби, солодощі і молочну продукцію.
Також потрібна відміна прийому деяких медикаментозних препаратів: антибіотики, підсилюючі чи послаблюючі засоби, свічки ректальні, олія рицинова та вазелінове.
Щоб правильно зібрати кал, необхідно провести гігієнічні заходи промежини і заднього проходу. Біоматеріал збирається природним чином, без застосування проносних засобів (Фортранс), клізм.

Якщо ви не знаєте, як правильно зібрати кал, проконсультуйтеся з представниками лабораторії. Заборонено використовувати в якості тари пластикові судочки, побутові банки зі скла. Необхідно придбати спеціальну стерильну ємність. Баночки для досліджень можна отримати в лабораторії або купити в аптеці. Зібраний кал слід щільно закрити.
Яку кількість дефекацій потрібно для проведення аналізу, можна уточнити у лаборанта. Зібраний біоматеріал слід доставити у лабораторію протягом двох годин. В іншому випадку результати можуть бути перекручені. Зберігати матеріал в холодильнику можна не більше 4 годин. Заборонено заморожувати в морозильній камері.
Бактеріологічний посів
Даний метод вважається застарілим. Однак він користується великим попитом. Основною перевагою цього аналізу вважається те, що його можна робити дорослим і дітям. Багато лікарі призначають його немовлятам, щоб виключити наявність патологій. Однак у бактеріологічного посіву є і негативні сторони.
Під час збору біоматеріалу здійснюється контакт з киснем, тому більша частина анаеробних мікроорганізмів гине. У свою чергу, це істотно впливає на результати. При даному аналізі не визначається мукозная мікрофлора з товстої кишки. Крім того, при транспортуванні калу в лабораторію гине безліч мікроорганізмів, які живуть в калових масах.
Розшифровка дослідження

Розшифровку результатів аналізу повинен робити лікар. Не варто самостійно намагатися встановити діагноз і призначати собі лікування.
Для немовлят нормою вважаються такі показники:
біфідобактерії – 1011; лактобактерії – 107; клостридії – 103; ентерококи – 107; пептострептококи – 105; мікроорганізми лактозонегативные – не більше 105 куо/г; ешерихії – 107; стафиококки патогенні – не повинно бути; бактероїди – 108; кандида – 103; сапрофітний стафілокок – 104; кальпротектін – відсутня; має бути слиз і кров, а забарвлення калових мас – чорний, сірий і зелений.
Розшифровка аналізу на дисбактеріоз у людей від 1 до 18 років:
біфідобактерії – 1010; лактобактерії – 108; клостридії – 105; ентерококи – 107; пептострептококи – 105; мікроорганізми лактозонегативные – не більше 105 куо/г; ешерихії – 108; стафиококки патогенні – не повинно бути; бактероїди – 108; кандида – 104; сапрофітний стафілокок – 104; кальпротектін – відсутня; має бути слиз і кров, а забарвлення калових мас – чорний, сірий і зелений.
Даний тест визначає кількість конкретних мікроорганізмів, що містяться в калових масах: стафілококи, ешерихії, клостридії, лакто – і біфідобактерії.
Діагностика піхвової мікрофлори
Крім кишкового дисбактеріозу, багатьох жінок мучить така патологія, як дисбіоз піхви. Дисбаланс мікрофлори піхви спостерігається в тому випадку, коли порушується рівновага патогенних і корисних бактерій. При розвитку дисбактеріозу значно переважає патогенна середовище. Клінічна картина: виділення зі статевих органів, сухість та біль у піхві, біль під час сексу, дискомфорт, а також свербіж. При виявленні подібних проявів слід звернутися до гінеколога, пройти огляд, а також здати відповідні аналізи на дисбактеріоз піхви.
Крім гінекологічного огляду, знадобляться такі дослідження: ПЛР-аналіз, мазок на флору і бактеріологічний посів виділень піхви. Дослідження на дисбіоз беруть одноразовим шпателем з трьох точок: зі стінок піхви, з отвору сечовидільного каналу, з цервікального каналу.
Даний аналіз відіграє вирішальну роль у процесі діагностики. На основі отриманих результатів лікар зможе побачити повну клінічну картину і призначити відповідне лікування.
